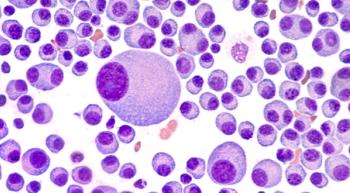

The past 20 years have brought great advances to advocacy groups, helping to improve patients’ quality of life. But more work is needed to raise awareness in underserved groups.
The past 20 years have brought great advances to advocacy groups, helping to improve patients’ quality of life. But more work is needed to raise awareness in underserved groups.

In honor of CURE®’s 20th anniversary, here is a roundup of some of the major advancements in the world of cancer care, according to experts, patients and advocates.

Over the past 20 years, chemotherapy has remained the primary treatment for triple-negative breast cancer. However, recent advancements have shown that a one-size-fits all treatment approach no longer works.

An expert offers insight into the major treatment improvements over the past 20 years for early-stage and late-stage lung cancer.

Twenty years of FDA approvals for the treatment of metastatic kidney cancer have allowed patients to live longer.

The time after cancer treatment can be overwhelming, but great progress in survivorship care plans over the past two decades has provided better guidance for an easier transition.

An expert provides insight on how primary uveal melanoma is often treated and sheds some light on an unmet need in treating the eye cancer.

Although some advancements to boost minority and female enrollment onto cancer clinical trials have occurred since the passing of a law 20 years ago, those improvements have begun to level off, according to an expert.

Thanks to the FDA approval of immunotherapy agents, the average survival for patients for stage 4 melanoma has drastically increased over the past 20 years, an expert explained.

The FDA approval of the first poly (adenosine diphosphate-ribose) polymerase, or PARP, inhibitor in the 2010s has drastically changed how patients with gynecologic cancers are treated.

Cancer treatment has evolved over the past 20 years, but has the way it is depicted in television and movies also changed?

Although much has changed in the past two decades, more needs to be done to prepare cancer survivors for what happens after their treatments end.

Mental wellbeing is more of a focus than ever before in cancer care, and while treatments continue to get better, there is still a long road ahead, according to Patrick Dempsey.

An expert discusses the side effects patients with kidney cancer may experience from immunotherapy and tyrosine kinase inhibitor treatment, and how more research is needed in to ensure patients experience less side effects.

Over the past 20 years, advancements in the lung cancer space have led to a drastic paradigm shift in how patients are now treated, ultimately leading to substantial improvements in survival and patient quality of life.

Monumental treatment advancements over the past two decades have given patients with thyroid cancer the ability to live longer and better lives, according to an expert from Cleveland Clinic’s Taussig Cancer Institute. However, more work is needed to find curative treatments.

Twenty years of updates in technology, techniques and available medications has provided more hope for patients with colorectal cancer, with more advances on the horizon.

Over the last 20 years, head and neck cancer treatment moved away from aggressive treatments for all patients to a more personalized approach — improving both outcomes and quality of life for patients with the disease.

In honor of CURE®’s 20th anniversary, we spoke with experts on how the past 20 years have revolutionized multiple myeloma treatment.

Aesthetic appearances, according to an expert at the UCSF, are often important for patients following the surgical treatment of cancer. Advancements in this space over the past 20 years have allowed many to patients to look as normal as possible.

Increased resources and technological advances have allowed cancer survivors experiencing psychological side effects to seek help that might not have been available to them 20 years ago.

A blood cancer specialist discusses how the development of tyrosine kinase inhibitors in the 1990s to treat chronic myelogenous leukemia drove major oncology advancements over the next three decades.

The executive director of the National LGBT Cancer Network discussed the past two decades of positive change in LGBTQ cancer care and highlighted what more still needs to be done.

A woman with metastatic breast cancer reflects on her pre-cancer life 20 years ago and how her perspective on the disease has shifted as she’s reached a level of acceptance and hope for the future.

When Joseph Heisler was diagnosed with von Hippel-Lindau disease 30 years ago, there was hardly any information on the condition. Fast forward three decades, there is an FDA-approved drug and a handbook of information available in two languages.